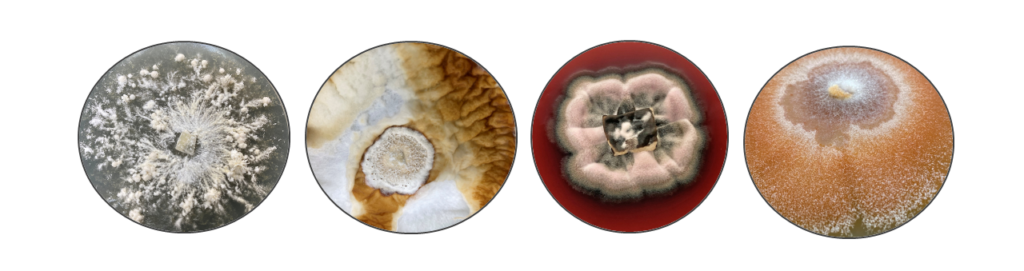

Pictures from fungal cultures in a storage cabinet and isolates in tubes.
Since 2000, the collection has been a member of the World Federation for Culture Collections (WFCC) under the acronym TFC – Tartu Fungal Culture Collection. By agreement, the Natural History Museum of the University of Tartu also has a fungal culture collection with the same acronym.

The Tartu Fungal Culture Collection (TFC) comprises material from various research groups. The earliest fungal strains in the Estonian University of Life Sciences collection were isolated during taxonomic research conducted by the research group of Erast Parmasto at the former Institute of Zoology and Botany, starting in 1970. These isolates number around 1,200 (with 1,109 strains digitized in the PlutoF database under the living cultures module). The collection represents approximately 370 fungal species. Among the Basidiomycota, wood-decaying fungi are the most abundantly represented group in the collection. The most species-rich genera include Hymenochaete (31 species, including the ex-holotype strain Hymenochaete koeljalgii Parmasto) and Phellinus (14 species). Several strains were obtained during expeditions to Central Asia and the Far East.
Examples of isolates in the forestry live culture collection (from the left)
Hericium erinaceum, Ganoderma lucidum, Dothiostroma septosporum, Neonectria fuckeliana
The forestry live culture collection (TFC-PAT) originated from research at the Forest Protection Sector of the Scientific Research Institute of Forestry in the Estonian SSR. The first pure cultures of tree fungal pathogens were isolated in 1965 by Märt Hanso, who studied Lophodermium species causing pine needle cast. Early work also explored biocontrol possibilities, targeting fungal antagonists for pine pathogens. Today, the Forest Pathology and Genetics Laboratory at the Estonian University of Life Sciences focuses on fungi damaging forests and wood. The laboratory holds approximately 7,000 fungal cultures, representing nearly 360 taxa, primarily from Ascomycota and Basidiomycota. Specimens document pathogens from Estonia and 40 other countries. These forestry cultures are utilized in applied research on biocontrol for forest pathogens, edible mushrooms, and international scientific collaborations.
The agricultural live culture collection (TFC-FP) primarily consists of pathogenic Ascomycota isolated from Estonian agricultural and horticultural crops. It is maintained at the phytopathology laboratory of the Institute of Agricultural and Environmental Sciences at Estonian University of Life Sciences. In addition to pathogenic fungi, the collection includes fungi used in biocontrol, such as Trichoderma, Clonostachys, and Pythium, sourced both locally and internationally. This collection is a valuable resource for population studies, regional plant protection strategies, and the development of biocontrol tools tailored to Estonian conditions. Researchers also investigate mycoviruses associated with fungal isolates to understand their impact on fungal pathogenicity and biocontrol efficacy. Since 2017, 1,500 strains have been isolated for this collection.

Trichoderma sp. covering Phytophthora infestans culture
Contact: Triin Varvas (triin.varvas@emu.ee)
Address: Fungal Culture Collection
Institute of Agricultural and Environmental Sciences
Estonian University of Life Sciences
Kreutzwaldi 5, 51006 Tartu
Estonia